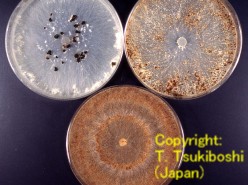

Japanese Fungi on Plants
No.64 before
next
top
 Thanatephorus
cucumeris (Frank) Donk [=Rhizoctonia solani
Kühn]
Thanatephorus
cucumeris (Frank) Donk [=Rhizoctonia solani
Kühn]
Classification: Basidiomycota, Hymenomycetes, Ceratobasidiales,
Ceratobasidiaceae
Distributed widely in Japan. Parasitizes most plant species and
frequently isolated from soil. Grouped to AG
(Anastomosis Group) 1-12 based on the hyphal anastomosis at pairing cultures and
IA -V cultural types on PDA. Disperses by elongating hyphae in soil or scattering
basidiospores. Surviving as sclerotia in soil and the teleomorph often produced
on the surface of soil or plant just upperground. Symbiotic to Orchidaceae
plants producing endomycorrhizae.
Characteristics: Saprophyte in soil, Plant pathogen, Endomycorrhiza
Symptoms: JPEG (Corn & Sorghum, Sheath blight,
39kb)
 |
 |
|
|
Morphology:
Teleomorph: Producing
sterigmata on basidia of doliform to short clavate. On stigma, producing
basidiospores hyaline, broad ellipsoidal to obovate, smooth, 6-14 x 4-8 um in size.
Anamorph: Hyphae
pale brown to brown, branching nearly at right angles, slightly
constricted at the point of branching, 6-10 um in width, without clamp
connections and conidia. |
| Hyphae (under fluorescens) |
Hyphae (nuclei staining) |
Colony appearance (upper left: AG1 IA, upper
light: AG1 IB, lower: AG2-2
IIIB) |
|
|
Herbarium specimen in NIAES
| Specimen No. |
Scientific name |
Host name |
Host scientific name |
Symptoms |
Geographical origin |
Collected date |
Collector |
| 250-1-25 |
Rhizoctonia solani |
Perennial ryegrass |
Lolium perenne |
Summer blight |
Nishinasuno, Tochigi |
1961.7.17 |
Tsuchiya, Y. |
| 250-1-26 |
" |
Italian ryegrass |
Lolium multiflorum |
" |
Nishinasuno, Tochigi |
" |
" |
(Described by Tsukiboshi, T., NIAES, Microbial Systemtics Lab.,
2002)
Copyright of the page belongs to
Natural Resources Inventory Center, NIAES.